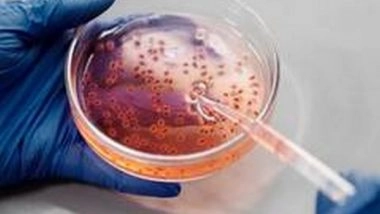
Health News | Loss of Circadian Regulation Allows for Increase in Glucose Production During Lung Cancer

Washington [US], June 28 (ANI): New research from the University of California, Irvine reveals how the circadian regulation of glucose production in the liver is lost during lung cancer progression, and how the resulting increase in glucose production may fuel cancer cell growth.
The new study titled, 'Glucagon regulates the stability of REV-ERBa to modulate hepatic glucose production in a model of lung cancer-associated cachexia', was published in the journal Science Advances. It illustrates how the circadian clock is regulated under conditions of stress such as during lung cancer progression and cancer-associated tissue wasting disease called cachexia.
"Our research shows that a critical circadian protein, REV-ERB, controls glucose production in the liver. During lung cancer progression and specifically under conditions of cachexia, this circadian regulation is lost, resulting in increased glucose production from the liver," said senior author Selma Masri, PhD, assistant professor in the Department of Biological Chemistry at UCI School of Medicine.
Selma added, "Based on our findings, we identified that lung tumours are able to provide instructive cues to the liver to increase glucose production, a major fuel source for cancer cells."
This research places the circadian clock as a central regulator of glucose production during lung cancer progression and provides important insight toward the development of novel therapeutics to target REV-ERB? to suppress cancer cell growth.
"We are continuing to investigate the consequence of increased glucose production during lung cancer progression by tracing the metabolic fate of this newly generated glucose to determine if this fuel source can drive the heightened metabolic demand of lung cancer cells," said Amandine Verlande, PhD, and Sung Kook Chun, PhD, postdoctoral scholars in the Masri Laboratory.
The circadian clock is our intrinsic biological pacemaker that maintains physiological homeostasis in all tissues of the body. Under conditions of stress, the biological clock is rewired as an adaptive mechanism to maintain synchrony and equilibrium throughout the body. (ANI)
(The above story is verified and authored by ANI staff, ANI is South Asia's leading multimedia news agency with over 100 bureaus in India, South Asia and across the globe. ANI brings the latest news on Politics and Current Affairs in India & around the World, Sports, Health, Fitness, Entertainment, & News. The views appearing in the above post do not reflect the opinions of LatestLY)













 Quickly
Quickly